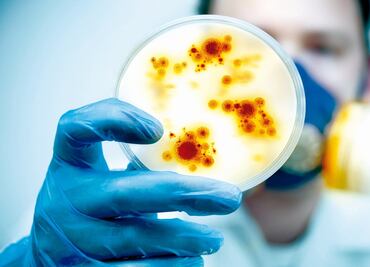
¿Qué es la brucelosis? Síntomas, causas y cómo tratar la enfermedad

Hay 77 muertes más, para un total de 289 mil 811 decesos en el país; CDMX, entidad con más defunciones

Hay 77 muertes más, para un total de 289 mil 811 decesos en el país; CDMX, entidad con más defunciones

Editorial

El ministerio de Salud del país informó que hay 2 mil 874 enfermos de cólera en al menos seis regiones en Níger; el grupo de edad entre 15 y 37 años es el más afectado por la epidemia

Qué difícil decisión para los siguientes nueve días. ¿Mando o no a mis hijos a los colegios? ¿Y si se contagian? ¿Y si mueren?

La tuberculosis causó la muerte de 1.4 millones de personas en 2019. Uno de los desafíos para combatir la enfermedad es que la bacteria que la causa puede "hibernar" y volverse activa muchos años después.

El estudio muestra cómo se pueden predecir los brotes de cólera en las regiones costeras de la India con una tasa de éxito del 89%
El gobierno busca controlar la narrativa y no el virus

Los descubrimientos exploran el colapso que tuvo una civilización, teniendo como hipótesis una epidemia prolongada

El tifo fue una enfermedad presente en el actual territorio mexicano desde la época de la Colonia. En 1915, durante la Revolución, fue considerada una epidemia y tuvieron que pasar 16 años para que se encontrara una vacuna capaz de combatirla masivamente, fue creada en este país por el mexicano Maximiliano Ruiz Castañeda y el germano-estadounidense Hans Zínsser
La ingesta de lácteos no pasteurizados o contacto con productos de animales enfermos son algunos de los transmisores de esta enfermedad